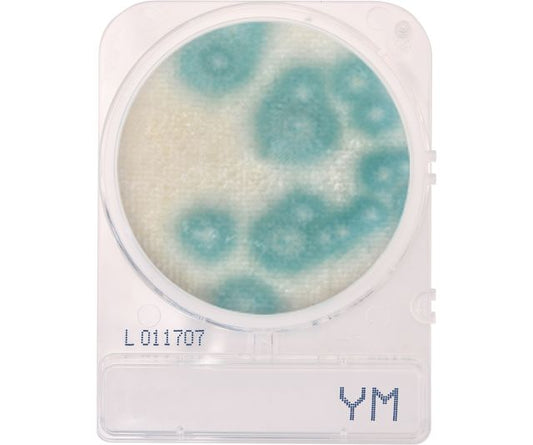
CompactDry Yeast/Mold (YM)  60 packages of 4 plates

-
Carboy, Round with Spigot and Handles, LDPE, White PP Screwcap, 10 Liter, Molded Graduations
Regular price $187.68 USDRegular priceUnit price / per -
Carboy, Round with Spigot and Handles, LDPE, White PP Screwcap, 20 Liter, Molded Graduations
Regular price $231.13 USDRegular priceUnit price / per -
Carboy, Round with Spigot and Handles, LDPE, White PP Screwcap, 50 Liter, Molded Graduations
Regular price $313.85 USDRegular priceUnit price / per -
Carboy, Round with Spigot and Handles, PP, White PP Screwcap, 10 Liter, Molded Graduations, Autoclavable
Regular price $211.55 USDRegular priceUnit price / per -
Carboy, Round with Spigot and Handles, PP, White PP Screwcap, 20 Liter, Molded Graduations, Autoclavable
Regular price $269.08 USDRegular priceUnit price / per -
Carboy, Round with Spigot and Handles, PP, White PP Screwcap, 50 Liter, Molded Graduations, Autoclavable
Regular price $372.61 USDRegular priceUnit price / per -
Cefsulodin-Irgasan Novobiocin (CIN) Agar / MacConkey Agar with Sorbitol, Biplate, 15x100mm
Regular price $46.54 USDRegular priceUnit price / per -
Centrifuge Tube, 15mL, Attached Red Screw Cap, STERILE, PS & PP
Regular price From $238.73 USDRegular priceUnit price / per -
Centrifuge Tube, 50mL, Polystyrene, STERILE, with Attached Red Screw Cap, 500 tubes, 25/bag
Regular price $360.56 USDRegular priceUnit price / per -
Centrifuge Tube, 50mL, STERILE, with Attached Blue Screw Cap
Regular price From $199.00 USDRegular priceUnit price / per -
Centrifuge Tubes, 15mL, Bulk, NON-STERILE, 500 tubes
Regular price From $152.50 USDRegular priceUnit price / per -
Centrifuge Tubes, 15mL, STERILE, Blue Cap, Polypropylene, Printed Graduations, 500 Tubes, Choose bag or rack
Regular price From $166.54 USDRegular priceUnit price / per -
Clip Hat - White, Double Stitched, 21" - 1 case of 1,000 hats (100/bag x 10)
Regular price $70.00 USDRegular priceUnit price / per -
CompactDry E. Coli (EC) and Coliforms for colony counting. 60 packages of 4 plates
Regular price $223.20 USDRegular priceUnit price / per -
CompactDry Enterobacteriaceae (ETB)
Regular price $163.21 USDRegular priceUnit price / per -
CompactDry Pseudomonas aeruginosa (PA)
Regular price $315.03 USDRegular priceUnit price / per -
CompactDry S. aureus (X-SA)
Regular price $235.20 USDRegular priceUnit price / per -
CompactDry Salmonella (SL), mini plates for colony counts. 60 packages of 4 plates
Regular price $247.20 USDRegular priceUnit price / per -
CompactDry TCR (Total Count Rapid) for aerobic colony counts
Regular price $187.20 USDRegular priceUnit price / per -
CompactDry Total Bacterial Plate Count (TC)
Regular price $163.20 USDRegular priceUnit price / per -
CompactDry Yeast/Mold (YM) 60 packages of 4 plates
Regular price $229.20 USDRegular priceUnit price / per -
CompactDry Yeast/Mold RAPID (YMR) for colony counts. 60 packages of 4 plates
Regular price $259.20 USDRegular priceUnit price / per -
Container, Multi-Purpose, 16oz (480mL), PP, Separate Snap Lid, White
Regular price $901.97 USDRegular priceUnit price / per -
Container, Multi-Purpose, 172oz (5160mL), PE, Separate Snap Lid, White
Regular price $517.65 USDRegular priceUnit price / per -
Container, Multi-Purpose, 190oz (5700mL), PE, Separate Snap Lid, White
Regular price $303.92 USDRegular priceUnit price / per -
Container, Multi-Purpose, 32oz (960mL), PE, Separate Snap Lid, White
Regular price $968.02 USDRegular priceUnit price / per -
Container, Multi-Purpose, 64oz (1920mL), PE, Separate Snap Lid, White
Regular price $827.66 USDRegular priceUnit price / per -
Container, Multi-Purpose, 86oz (2580mL), PP, Separate Snap Lid, White
Regular price $755.32 USDRegular priceUnit price / per -
Container, Multi-Purpose, 8oz (240mL), PP, Separate Snap Lid, White
Regular price $618.58 USDRegular priceUnit price / per -
Container, Multi-Purpose, PE, Economy Style, 16oz (480mL), Separate Snap Lid, Natural
Regular price $100.83 USDRegular priceUnit price / per -
Container, Multi-Purpose, PE, Economy Style, 16oz (480mL), Separate Snap Lid, White
Regular price $100.83 USDRegular priceUnit price / per -
Container, Multi-Purpose, PE, Economy Style, 172oz, (5160mL), Separate Snap Lid, Natural
Regular price $65.43 USDRegular priceUnit price / per -
Container, Multi-Purpose, PE, Economy Style, 172oz, (5160mL), Separate Snap Lid, White
Regular price $65.43 USDRegular priceUnit price / per -
Container, Multi-Purpose, PE, Economy Style, 64oz (1920mL), Separate Snap Lid, Natural
Regular price $164.60 USDRegular priceUnit price / per -
Container, Multi-Purpose, PE, Economy Style, 64oz (1920mL), Separate Snap Lid, White
Regular price $164.60 USDRegular priceUnit price / per -
Container, Multi-Purpose, PE, Economy Style, 86oz (2580mL), Separate Snap Lid, Natural
Regular price $97.83 USDRegular priceUnit price / per